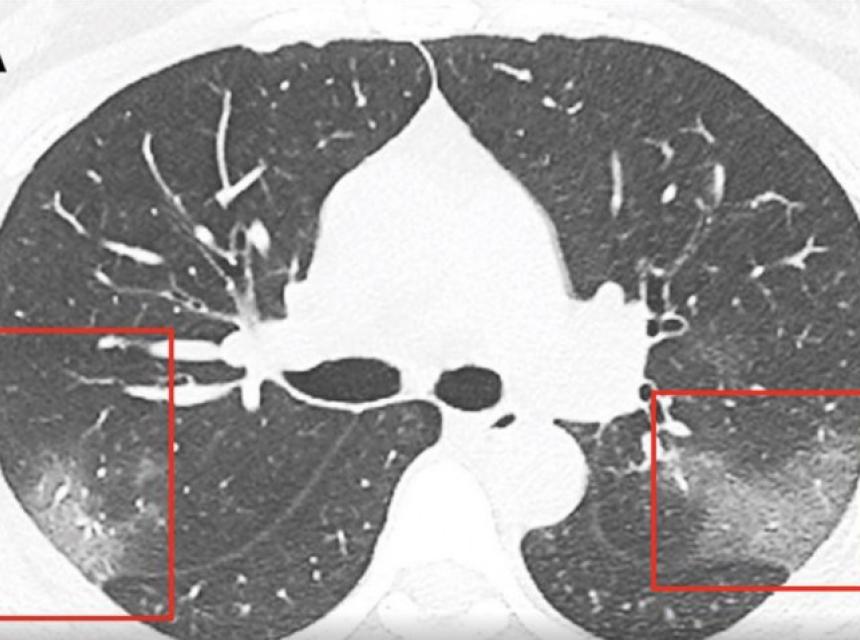

Ljekari su objavili šokantan CT snimak koji najbolje pokazuje šta koronavirus radi plućima.
Na CT snimcima ljekari su uočili bijele sjene, poput takozvanog mliječnog stakla, što ih je upozorilo na to da su pluća djelimično ispunjena tekućinom.
Snimci pluća predstavljeni su u naučnom časopisu "Radiology", a tekst potpisuje grupa ljekara istraživača Prve univerzitetske bolnice u Lanzou.
Navode da kod pacijenata zaraženih koronavirusom dolazi do infekcije koja može oštetiti pluća ili izazvati upalu opasnu po život. Dolazi do oticanja pluća i nagomilavanja tekućine u njima. Pacijenti se zbog toga stavljaju na terapiju lijekovima koji pomažu u otvaranju dišnih kanala.
Ljekari koronavirus identificiraju brisom iz nosa ili usta, a ističu da je test efikasan pokazatelj zaraze samo ako postoje simptomi oboljenja.
Podsjećamo, od koronavirusa su umrle 362 osobe, a više od 17.000 njih je zaraženo.